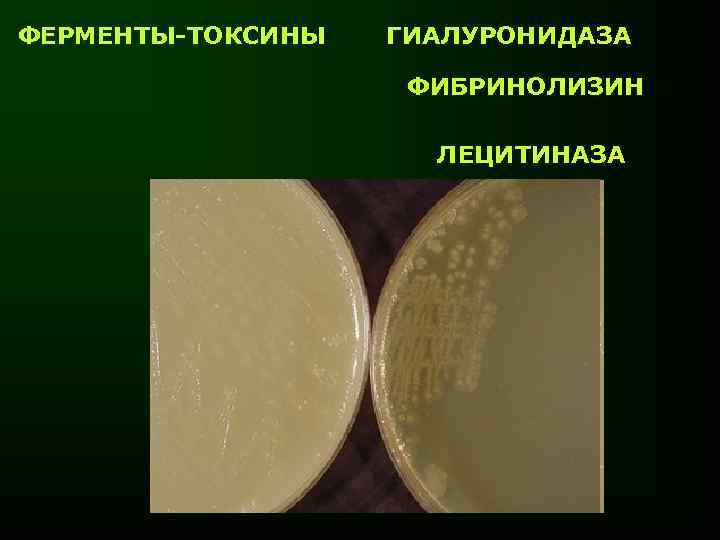
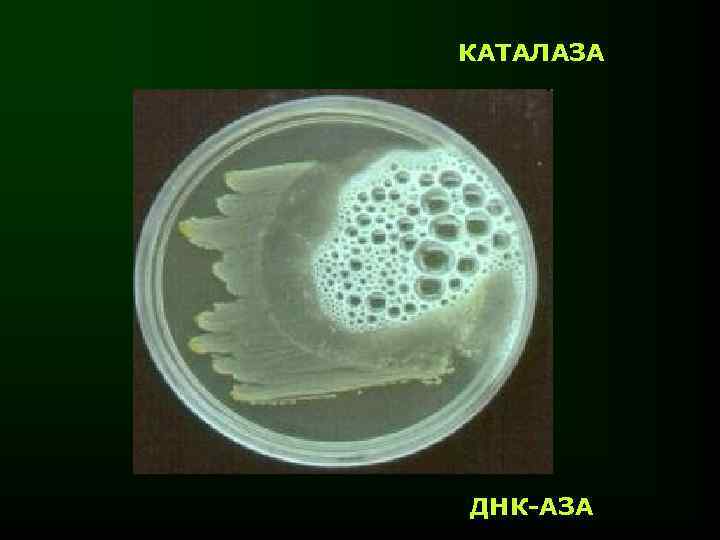
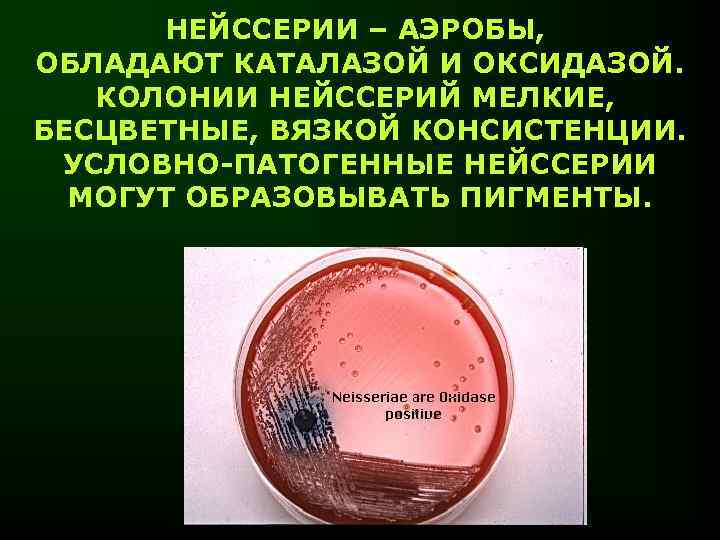

Курс лекций - кокки.ppt
- Количество слайдов: 74

ЛЕКЦИЯ ШАРОВИДНЫЕ БАКТЕРИИ – КОККИ. ОБЩАЯ ХАРАКТЕРИСТИКА. ЗНАЧЕНИЕ В ПАТОЛОГИИ ЧЕЛОВЕКА

СРЕДИ КОККОВЫХ БАКТЕРИЙ, ИМЕЮЩИХ ЗНАЧЕНИЕ ДЛЯ ЧЕЛОВЕКА В КАЧЕСТВЕ ПРЕДСТАВИТЕЛЕЙ АУТОМИКРОФЛОРЫ И ВОЗБУДИТЕЛЕЙ ИНФЕКЦИОННЫХ ЗАБОЛЕВАНИЙ, ОСОБОЕ МЕСТО ЗАНИМАЮТ • СТАФИЛОКОККИ, • СТРЕПТОКОККИ, • НЕЙССЕРИИ

СТАФИЛОКОККИ СЕМЕЙСТВО MICROCOCCACEAE РОД STAPHYLOCOCCUS ВИДЫ S. AUREUS S. EPIDERMIDIS S. SAPROPHYTICUS СТАФИЛОКОККИ ОТКРЫТЫ ЛУИ ПАСТЕРОМ В 1880 г.

ОБЩАЯ ХАРАКТЕРИСТИКА Грам + КОККИ. НЕПОДВИЖНЫ. ХЕМООРГАНОТРОФЫ. ФАКУЛЬТАТИВНЫЕ АНАЭРОБЫ. РОДОВОЙ ПРИЗНАК: СПОСОБНОСТЬ К РОСТУ В ПРИСУТСТВИИ 6 – 10% Na. Cl (СОЛЕВОЙ МПА – СЕЛЕКТИВНАЯ СРЕДА). АНТИГЕНАМИ ЯВЛЯЮТСЯ СТРУКТУРЫ КЛЕТКИ (МИКРОКАПСУЛА, КЛЕТОЧНАЯ СТЕНКА И ДР. ), НО ДЛЯ ДИФФЕРЕНЦИРОВКИ АНТИГЕНЫ ЗНАЧЕНИЯ НЕ ИМЕЮТ



КОЛОНИИ СТАФИЛОКОККОВ 2 – 3 мм В ДИАМЕТРЕ, КРУГЛЫЕ, С РОВНЫМИ КРАЯМИ, ВЫПУКЛЫЕ, ПИГМЕНТИРОВАННЫЕ. В ЖИДКИХ СРЕДАХ СТАФИЛОКОККИ ОБРАЗУЮТ РАВНОМЕРНОЕ ПОМУТНЕНИЕ

S. aureus – ОБЛИГАТНО-ПАТОГЕННЫЙ ВИД, ОБЪЕДИНЯЮЩИЙ МНОЖЕСТВО ШТАММОВ, ДЕСЯТКИ СЕРОВАРОВ И ФАГОВАРОВ, А ТАКЖЕ 6 ЭКОВАРОВ, ОТЛИЧАЮЩИХСЯ ХОЗЯЕВАМИ S. epidermidis S. aureus интактная среда ДИФФЕРЕНЦИРОВКА S. аureus ПРОВОДИТСЯ НА ОСНОВЕ ФЕРМЕНТАЦИИ МАННИТА В АНАЭРОБНЫХ УСЛОВИЯХ, А ТАКЖЕ – ПО НАЛИЧИЮ ФАКТОРОВ ПАТОГЕННОСТИ

ФАКТОРЫ ПАТОГЕННОСТИ S. aureus МИКРОКАПСУЛА СТРУКТУРЫ БАКТЕРИАЛЬНОЙ КЛЕТКИ ТЕЙХОЕВЫЕ КИСЛОТЫ ПРОТЕИН А УСИЛЕНИЕ ФАГОЦИТОЗА C 1 r … С 1 q C 1 s
ФЕРМЕНТЫ-ТОКСИНЫ ГИАЛУРОНИДАЗА ФИБРИНОЛИЗИН ЛЕЦИТИНАЗА

ПЛАЗМОКОАГУЛАЗА отрицательная проба положительная проба
КАТАЛАЗА ДНК-АЗА

β-ЛАКТАМАЗЫ

ЭКЗОТОКСИНЫ МЕМБРАНОТРОПНЫЕ: ЛЕЙКОЦИДИН, ГЕМОЛИЗИНЫ

ЭНТЕРОТОКСИНЫ (A, B, C, D, E, F) ЭКСФОЛИАТИВНЫЙ ТОКСИН, ВЫЗЫВАЮЩИЙ СИНДРОМ ТОКСИЧЕСКОГО ШОКА

S. аureus ЯВЛЯЕТСЯ ПРИЧИНОЙ ПИОГЕННЫХ (НАГНОИТЕЛЬНЫХ) ЗАБОЛЕВАНИЙ ЛЮБОЙ ЛОКАЛИЗАЦИИ (ФУРУНКУЛЫ, АБСЦЕССЫ, ПИОДЕРМИИ, ПНЕВМОНИИ, ОСТЕОМИЕЛИТЫ и др. ), А ТАКЖЕ – ГЕНЕРАЛИЗОВАННЫХ ФОРМ – СЕПСИСА, СЕПТИКОПИЕМИИ, СИНДРОМА ТОКСИЧЕСКОГО ШОКА (СТШ)

СТАФИЛОКОККИ ШИРОКО РАСПРОСТРАНЕНЫ В ОКРУЖАЮЩЕЙ СРЕДЕ, ЗАРАЖЕНИЕ МОЖЕТ ПРОИСХОДИТЬ ЛЮБЫМ ПУТЁМ (КОНТАКТНЫМ, ВОЗДУШНО-КАПЕЛЬНЫМ, АЛИМЕНТАРНЫМ и др. )

СТРЕПТОКОККИ СЕМЕЙСТВО STREPTOCOCCACEAE РОД ВИДЫ STREPTOCOCCUS S. PYOGENES S. PNEUMONIAE S. FAECALIS СТРЕПТОКОККИ ОТКРЫТЫ БИЛЬРОТОМ В 1874 г. , А ПОЗЖЕ - ЛУИ ПАСТЕРОМ

ОБЩАЯ ХАРАКТЕРИСТИКА Грам + КОККИ. НЕПОДВИЖНЫ. ХЕМООРГАНОТРОФЫ. ФАКУЛЬТАТИВНЫЕ АНАЭРОБЫ. ИМЕЮТ МИКРОКАПСУЛУ

S. PNEUMONIAE – ПНЕВМОКОКК В ТКАНИ ЛЁГКОГО

СТРЕПТОКОККИ НУЖДАЮТСЯ В НАТИВНОМ БЕЛКЕ – КРОВЯНОЙ АГАР, СЫВОРОТОЧНЫЙ АГАР КОЛОНИИ СТРЕПТОКОККОВ МЕЛКИЕ, ПОЛУПРОЗРАЧНЫЕ, БЕСЦВЕТНЫЕ, НА КРОВЯНОМ АГАРЕ ОБРАЗУЮТ ЗОНЫ ГЕМОЛИЗА.

В ОСНОВЕ ДИФФЕРЕНЦИРОВКИ БИОХИМИЧЕСКАЯ АКТИВНОСТЬ СТРЕПТОКОККОВ – СТРЕПТОКОККОВ ВАРИАБЕЛЬНА И НЕ АНТИГЕННАЯ СТРУКТУРА ИМЕЕТ ДИАГНОСТИЧЕСКОГО ЗНАЧЕНИЯ ПРОТЕИНЫ КЛЕТ. СТ. (M, T, R) КАПСУЛА ПОЛИСАХАРИДНЫЙ КОМПОНЕНТ КЛЕТОЧНОЙ СТЕНКИ (РАМНОЗА+N-АЦЕТИЛ-b-DГЛЮКОЗАМИН) ЦПМ

СХЕМА Lancefield (1933 г. ) ПОЛИСАХАРИДНЫЙ БЕЛКОВЫЙ АНТИГЕН – ГРУППОВОЙ ТИПОСПЕЦИФИЧНЫЙ (17 серогрупп) СЕРОГРУППА А БОЛЕЕ 100 СЕРОВАРОВ ПО ПРОТЕИНУ М (А 1…) СЕРОГРУППА В … СЕРОГРУППА С … …

СТРЕПТОКОККИ ВЫЗЫВАЮТ У ЧЕЛОВЕКА 4 ТИПА ЗАБОЛЕВАНИЙ В СООТВЕТСТВИИ С ИМЕЮЩИМИСЯ У ВОЗБУДИТЕЛЯ ФАКТОРАМИ ПАТОГЕННОСТИ. ПУТИ ПЕРЕДАЧИ СТРЕПТОКОККОВЫХ ИНФЕКЦИЙ: ВОЗДУШНО-КАПЕЛЬНЫЙ, КОНТАКТНЫЙ, АЛИМЕНТАРНЫЙ

1. ПИОГЕННЫЕ ИНФЕКЦИИ (ФУРУНКУЛЫ, СТРЕПТОДЕРМИИ, РОЖА, АНГИНЫ, БРОНХИТЫ и др. ) РАЗВИВАЮТСЯ ПРИ ВНЕДРЕНИИ В ОРГАНИЗМ ШТАММОВ S. pyogenes, S. pneumoniae, ПРОДУЦИРУЮЩИХ ФЕРМЕНТЫ-ТОКСИНЫ И ОБЛАДАЮЩИХ СПОСОБНОСТЬЮ ИНГИБИРОВАТЬ ФАГОЦИТОЗ И АКТИВАЦИЮ КОМПЛЕМЕНТА СХОДНЫЕ ПРОЦЕССЫ МОГУТ ВЫЗЫВАТЬ СТРЕПТОКОККИ СЕРОГРУПП В, С, D, ОТНОСЯЩИЕСЯ К УСЛОВНО-ПАТОГЕННЫМ ШТАММАМ

ХРОНИЧЕСКОЕ РОЖИСТОЕ ВОСПАЛЕНИЕ

2. НЕГНОЙНЫЕ ХРОНИЧЕСКИЕ ЗАБОЛЕВАНИЯ, В ПАТОГЕНЕЗЕ КОТОРЫХ ПРЕОБЛАДАЮТ ПРИЗНАКИ АУТОИММУННОГО ПОРАЖЕНИЯ ВСЛЕДСТВИЕ КРОСС-РЕАКТИВНОСТИ АНТИГЕНОВ СТРЕПТОКОККОВ И СТРУКТУР ОРГАНИЗМА ЧЕЛОВЕКА. ВЫЗЫВАЮТСЯ ТЕМИ ЖЕ ШТАММАМИ, ЧТО И ПРЕДЫДУЩИЕ ПРОЦЕССЫ. РЕВМАТИЗМ, ГЛОМЕРУЛОНЕФРИТ

3. ОСТРЫЕ ИНФЕКЦИОННЫЕ ЗАБОЛЕВАНИЯ, В ПАТОГЕНЕЗЕ КОТОРЫХ ОСНОВНОЕ ЗНАЧЕНИЕ ИМЕЕТ ЭКЗОТОКСИН. ВЫЗЫВАЮТСЯ ШТАММАМИ S. pyogenes ПРОДУЦЕНТАМИ ДАННОГО ЭКЗОТОКСИНА. В ЗАБОЛЕВАНИИ ПРЕОБЛАДАЮТ ПРИЗНАКИ СЕПТИЧЕСКОГО ВОСПАЛЕНИЯ, И/ИЛИ ГЕНЕРАЛИЗОВАННОГО ИММУНООПОСРЕДОВАННОГО ВОСПАЛЕНИЯ. СКАРЛАТИНА

4. КАРИЕС – ЗАБОЛЕВАНИЕ ЗУБОВ ВЫЗЫВАЮТСЯ ГРУППОЙ КАРИЕСОГЕННЫХ СТРЕПТОКОККОВ – ПРЕДСТАВИТЕЛЕЙ АУТОМИКРОФЛОРЫ ПОЛОСТИ РТА. S. MUTANS, S. SALIVARIUS, S. SANGUIS, S. MITIS и др. ПАТОГЕННОСТЬ СВЯЗАНА С АДГЕЗИЕЙ НА ЭМАЛИ ЗУБА, КОЛОНИЗАЦИЕЙ И ФЕРМЕНТАЦИЕЙ УГЛЕВОДОВ С ОБРАЗОВАНИЕМ КИСЛОТЫ, КОТОРАЯ НАПРАВЛЕННО ВОЗДЕЙСТВУЕТ НА ЭМАЛЬ В ЗОНЕ РАСПОЛОЖЕНИЯ КОЛОНИЙ (БЛЯШЕК)

ФАКТОРЫ ПАТОГЕННОСТИ S. PYOGENES СТРУКТУРЫ БАКТЕРИАЛЬНОЙ КЛЕТКИ КАПСУЛА (ГИАЛУРОНОВАЯ КИСЛОТА, НЕАНТИГЕННА, ЭКРАНИРУЕТ АНТИГЕНЫ КЛЕТОЧНОЙ СТЕНКИ ОТ РАСПОЗНАВАНИЯ КЛЕТКАМИ ИММУННОЙ СИСТЕМЫ)

М-ПРОТЕИН (ИНГИБИТОР ФАГОЦИТОЗА – АНАЛОГИЧНО ПРОТЕИНУ А СТАФИЛОКОККОВ, АДГЕЗИН) F-ПРОТЕИН (ИНГИБИТОР ФАГОЦИТОЗА, АДГЕЗИН)

ФЕРМЕНТЫ- ТОКСИНЫ СТРЕПТОКИНАЗА (ФИБРИНОЛИЗИН) ДНК-АЗА, РНК-АЗА, АТФ-АЗА ГИАЛУРОНИДАЗА (У ПНЕВМОКОККА)

ЭКЗОТОКСИНЫ Sic (streptococcal inhibitor of complement) – СТРЕПТОКОККОВЫЙ ИНГИБИТОР КОМПЛЕМЕНТА СТРЕПТОКОККОВЫЕ ПИРОГЕННЫЕ ЭКЗОТОКСИНЫ (streptococcal pyrogenic exotoxins) Spe. А, В, С, -СУПЕРАНТИГЕНЫ

О-СТРЕПТОЛИЗИН РАЗРУШАЕТ МЕМБРАНЫ КЛЕТОК (ЭРИТРОЦИТОВ и др. ), КАРДИОТОКСИЧЕН, АНТИГЕНЕН S-СТРЕПТОЛИЗИН НУКЛЕОПРОТЕИД, РАЗРУШАЕТ ЛИЗОСОМЫ, ВЫСВОБОЖДАЮЩИЕСЯ ПРИ ЭТОМ ФЕРМЕНТЫ ВЫЗЫВАЮТ ДЕСТРУКЦИЮ ТКАНЕЙ, НЕАНТИГЕНЕН

ЭРИТРОГЕННЫЙ ТОКСИН (ЭРИТРОГЕНИН) – А, В, С – КОДИРУЕТСЯ ТРАНСДУЦИРУЮЩИМ ФАГОМ, РАЗРУШАЕТ ЭНДОТЕЛИЙ КАПИЛЛЯРОВ, ПИРОГЕН. СУПЕРАНТИГЕН. ОСНОВНОЙ ФАКТОР ПАТОГЕННОСТИ ПРИ СКАРЛАТИНЕ

ДЕЙСТВИЕ ЭРИТРОГЕНИНА: «МАЛИНОВЫЙ» ЯЗЫК У БОЛЬНОГО СКАРЛАТИНОЙ РЕБЁНКА

ДЕЙСТВИЕ ЭРИТРОГЕНИНА: СЫПЬ НА КОЖЕ ПРИ СКАРЛАТИНЕ

ФАКТОРЫ ЗАЩИТЫ ОРГАНИЗМА ОТ СТАФИЛОКОККОВ И СТРЕПТОКОККОВ НА УРОВНЕ ФИЗИОЛОГИЧЕСКИХ НЕСПЕЦИФИЧЕСКИХ РЕАКЦИЙ ЦЕЛОСТНОСТЬ ПОКРОВНЫХ ТКАНЕЙ ПОТЕНЦИАЛ АУТОМИКРОФЛОРЫ

НА УРОВНЕ ВИДОВОГО (АНТИГЕННЕСПЕЦИФИЧЕСКОГО) ИММУНИТЕТА - ЛИЗОЦИМ ФАГОЦИТОЗ

НА УРОВНЕ ПРИОБРЕТЁННОГО (АНТИГЕНСПЕЦИФИЧЕСКОГО) ИММУНИТЕТА АНТИТЕЛА: • НЕЙТРАЛИЗУЮТ ЭКЗОТОКСИНЫ И ФЕРМЕНТЫ-ТОКСИНЫ, • ОПСОНИЗИРУЮТ СТАФИЛОКОККИ, УСИЛИВАЯ ФАГОЦИТОЗ И АКТИВИРУЯ КЛАССИЧЕСКИЙ ПУТЬ СИСТЕМЫ КОМПЛЕМЕНТА, ЧТО ПРИВОДИТ К ДЕСТРУКЦИИ БАКТЕРИЙ

ЛЕЧЕНИЕ СТАФИЛО- И СТРЕПТОКОККОВЫХ ИНФЕКЦИЙ ХИМИОТЕРАПЕВТИЧЕСКИЕ СРЕДСТВА • АНТИСЕПТИКИ • АНТИБИОТИКИ ПРЕПАРАТЫ СПЕЦИФИЧЕСКОЙ ИММУНОТЕРАПИИ (СТАФИЛОКОККИ) • АНТИСТАФИЛОКОККОВЫЙ ИММУНОГЛОБУЛИН, • АНТИСТАФИЛОКОККОВАЯ ПЛАЗМА, • СТАФИЛОКОККОВАЯ АУТОВАКЦИНА

ПРОФИЛАКТИКА СТАФИЛО- И СТРЕПТОКОККОВЫХ ИНФЕКЦИЙ НЕСПЕЦИФИЧЕСКАЯ НЕ ПРИМЕНЯЕТСЯ

ДИАГНОСТИКА СТАФИЛО- И СТРЕПТОКОККОВЫХ ИНФЕКЦИЙ МИКРОБИОЛОГИЧЕСКАЯ

НЕЙССЕРИИ СЕМЕЙСТВО РОД ВИДЫ NEISSERIACEAE NEISSERIA MORAXELLA BRANHAMELLA N. MENINGITIDIS N. GONORRHOEAE N. MUCOSA, N. SUBFLAVA ГОНОКОКК ОПИСАН А. НЕЙССЕРОМ В 1879 г. , МЕНИНГОКОКК – А. ВАКСЕЛЬБАУМОМ В 1887 г.

ОБЩАЯ ХАРАКТЕРИСТИКА Грам- ДИПЛОКОККИ. НЕПОДВИЖНЫ. ХЕМООРГАНОТРОФЫ. СПОР НЕ ОБРАЗУЮТ. В РОДУ ЕСТЬ КАК ПРЕДСТАВИТЕЛИ АУТОМИКРОФЛОРЫ, ТАК И ОБЛИГАТНО-ПАТОГЕННЫЕ ВИДЫВОЗБУДИТЕЛИ АНТРОПОНОЗНЫХ ИНФЕКЦИЙ

НЕЙССЕРИИ – АЭРОБЫ, ОБЛАДАЮТ КАТАЛАЗОЙ И ОКСИДАЗОЙ. КОЛОНИИ НЕЙССЕРИЙ МЕЛКИЕ, БЕСЦВЕТНЫЕ, ВЯЗКОЙ КОНСИСТЕНЦИИ. УСЛОВНО-ПАТОГЕННЫЕ НЕЙССЕРИИ МОГУТ ОБРАЗОВЫВАТЬ ПИГМЕНТЫ.

ПАТОГЕННЫЕ НЕЙССЕРИИ ИМЕЮТ МИКРОКАПСУЛУ. ЯВЛЯЮТСЯ ОБЛИГАТНЫМИ ВНУТРИКЛЕТОЧНЫМИ ПАРАЗИТАМИ.


ПАТОГЕННЫЕ НЕЙССЕРИИ В ИСКУССТВЕННЫХ УСЛОВИЯХ НУЖДАЮТСЯ В НАТИВНОМ БЕЛКЕ. НЕ РАЗМНОЖАЮТСЯ ПРИ КОМНАТНОЙ ТЕМПЕРАТУРЕ. ОБЛАДАЮТ СЛАБОЙ САХАРОЛИТИЧЕСКОЙ АКТИВНОСТЬЮ

«ПЁСТРЫЙ РЯД» - БИОХИМИЧЕСКАЯ ДИФФЕРЕНЦИРОВКА НЕЙССЕРИЙ – слева – направо: глюкоза – мальтоза - сахароза NEISSERIA MENINGITIDIS NEISSERIA GONORRHOEAE MORAXELLA CATARRHALIS

АНТИГЕННАЯ СТРУКТУРА МЕНИНГОКОККОВ В ОСНОВЕ СЕРОЛОГИЧЕСКОЙ ДИФФЕРЕНЦИРОВКИ МЕНИНГОКОККОВ – КАПСУЛЬНЫЙ АНТИГЕН (ПОЛИСАХАРИД) – ПО СПЕЦИФИЧНОСТИ КОТОРОГО ВЫДЕЛЕНЫ СЕРОВАРЫ: A, B, C, D, X, Y, Z, W-135, 29 E РАЗДЕЛЕНИЕ МЕНИНГОКОККОВ НА ПОДВАРИАНТЫ (ОБОЗНАЧАЮТСЯ АРАБСКИМИ ЦИФРАМИ) ПРОИЗВОДИТСЯ НА ОСНОВЕ РАЗЛИЧИЙ БЕЛКОВОЙ КОМПОНЕНТЫ КЛЕТОЧНОЙ СТЕНКИ

ФАКТОРЫ ПАТОГЕННОСТИ МЕНИНГОКОККА СТРУКТУРЫ БАКТЕРИАЛЬНОЙ КЛЕТКИ КАПСУЛА ИНГИБИРУЕТ ФАГОЦИТОЗ (НЕЗАВЕРШЁННЫЙ ХАРАКТЕР), СПОСОБСТВУЕТ АДГЕЗИИ К КЛЕТКАМ ПИЛИ (ФИМБРИИ) СПОСОБСТВУЮТ АДГЕЗИИ К КЛЕТКАМ

ЛИПОПОЛИСАХАРИД (ЛПС) КЛЕТОЧНОЙ СТЕНКИ – ЭНДОТОКСИН – ВЫСВОБОЖДАЕТСЯ В ПРОЦЕССЕ ЛИЗИСА БАКТЕРИЙ В КРОВЕНОСНОМ РУСЛЕ ВСЛЕДСТВИЕ АКТИВАЦИИ АЛЬТЕРНАТИВНОГО ПУТИ КОМПЛЕМЕНТА

ФЕРМЕНТЫ-ТОКСИНЫ НЕЙРАМИНИДАЗА ГИАЛУРОНИДАЗА

МЕНИНГОКОККИ ВЫЗЫВАЮТ МЕНИНГОКОККОВУЮ ИНФЕКЦИЮ, ПЕРЕДАВАЕМУЮ ВОЗДУШНО-КАПЕЛЬНЫМ ПУТЁМ (РЕЖЕ – КОНТАКТНЫМ) З А Р А Ж Е Н И Е БЕССИМПТОМНОЕ НОСИТЕЛЬСТВО (75 – 80 %) ЛОКАЛЬНАЯ ФОРМА (НАЗОФАРИНГИТ) ГЕНЕРАЛИЗОВАННЫЕ ФОРМЫ (МЕНИНГИТ, МЕНИНГОКОКЦЕМИЯ)

ПАТОГЕНЕЗ МЕНИНГОКОККОВОЙ ИНФЕКЦИИ ВХОДНЫЕ ВОРОТА – СЛИЗИСТАЯ ОБОЛОЧКА НОСОГЛОТКИ ПРОНИКНОВЕНИЕ В КРОВЬ, РАЗРУШЕНИЕ ЧАСТИ ПОПУЛЯЦИИ РАЗМНОЖЕНИЕ В КРОВИ, ЭНДОТЕЛИИ СОСУДОВ, ЦИРКУЛЯЦИЯ В КРОВИ КОЛОНИЗАЦИЯ МЕНИНГОКОККА, ВЕГЕТАЦИЯ САНАЦИЯ ПРИ АДЕКВАТНОМ ИММУННОМ ОТВЕТЕ. ВЫЗДОРОВЛЕНИЕ ПРОНИКНОВЕНИЕ В МЯГКИЕ МОЗГОВЫЕ ОБОЛОЧКИ, МОЗГ, РАЗВИТИЕ ВОСПАЛЕНИЯ, НЕОБРАТИМОЕ РАЗРУШЕНИЕ ТКАНЕЙ

СЫПЬ НА КОЖЕ ПРИ МЕНИНГОКОКЦЕМИИ

ФАКТОРЫ ЗАЩИТЫ ОРГАНИЗМА ОТ МЕНИНГОКОККОВОЙ ИНФЕКЦИИ НА УРОВНЕ ВИДОВОГО (АНТИГЕННЕСПЕЦИФИЧЕСКОГО) ИММУНИТЕТА – СИСТЕМА КОМПЛЕМЕНТА НА УРОВНЕ ПРИОБРЕТЁННОГО (АНТИГЕНСПЕЦИФИЧЕСКОГО) ИММУНИТЕТА - АНТИТЕЛА

ПОСЛЕ ПЕРЕНЕСЁННОЙ МЕНИНГОКОККОВОЙ ИНФЕКЦИИ ДЛИТЕЛЬНОЕ ВРЕМЯ (ВОЗМОЖНО ПОЖИЗНЕННО) СОХРАНЯЕТСЯ ИММУНИТЕТ, НО ТОЛЬКО К СЕРОВАРУ ВОЗБУДИТЕЛЯ

РАЗРАБОТАНА СПЕЦИФИЧЕСКАЯ ПРОФИЛАКТИКА МЕНИНГОКОККОВОЙ ИНФЕКЦИИ – ХИМИЧЕСКАЯ ВАКЦИНА, СОДЕРЖАЩАЯ ПОЛИСАХАРИДНЫЕ АНТИГЕНЫ ВСЕХ 3 (А, В, С) НАИБОЛЕЕ ЧАСТО ВСТРЕЧАЮЩИХСЯ СЕРОВАРОВ

ОСНОВУ ЛЕЧЕНИЯ МЕНИНГОКОККОВОЙ ИНФЕКЦИИ СОСТАВЛЯЮТ АНТИБИОТИКИ ДИАГНОСТИКА ОСУЩЕСТВЛЯЕТСЯ МИКРОСКОПИЧЕСКИМ, КУЛЬТУРАЛЬНЫМ И СЕРОЛОГИЧЕСКИМ МЕТОДАМИ

АНТИГЕННАЯ СТРУКТУРА ГОНОКОККОВ ОСНОВНОЙ АНТИГЕН – ПРОТЕИН ПИЛЕЙ. ОПИСАНО БОЛЕЕ 16 СЕРОВАРОВ. ХАРАКТЕРНА АНТИГЕННАЯ ИЗМЕНЧИВОСТЬ, ЧТО ЯВЛЯЕТСЯ ПРИЧИНОЙ ОТСУТСТВИЯ ПРОТЕКТИВНОГО ЭФФЕКТА АНТИТЕЛ

ГЛАВНЫЙ ПОВЕРХНОСТНЫЙ БЕЛОК ПИЛИН МЕНЯЕТСЯ НЕ ЗА СЧЕТ ОБЫЧНЫХ «СЛУЧАЙНЫХ МУТАЦИЙ» — ОШИБОК ПРИ КОПИРОВАНИИ ГЕНОМА, А ЗА СЧЕТ КОНТРОЛИРУЕМОГО ПРОЦЕССА ГЕННОЙ КОНВЕРСИИ, ТО ЕСТЬ ВПОЛНЕ ЦЕЛЕНАПРАВЛЕННОЙ ЗАМЕНЫ ОДНИХ УЧАСТКОВ ГЕНА ДРУГИМИ. ЭТОТ МЕХАНИЗМ БЛИЗОК РЕАРАНЖИРОКЕ ГЕНОВ В ПРОЦЕССЕ ОБРАЗОВАНИЯ АНТИТЕЛ.

Репликация ДНК у гонококка. Цифрами обозначено время в минутах. В исходной клетке (слева вверху)— 2 гомологичные кольцевые хромосомы, содержащие один и тот же набор генов. В процессе подготовки к делению обе хромосомы начинают реплицироваться одновременно. В результате получается клетка с четырьмя хромосомами. Она делится пополам, причем каждая дочерняя клетка получает по 2 копии одной из двух исходных хромосом. Рис. из статьи в PLo. S Biology

ФАКТОРЫ ПАТОГЕННОСТИ ГОНОКОККА СТРУКТУРЫ БАКТЕРИАЛЬНОЙ КЛЕТКИ КАПСУЛА ИНГИБИРУЕТ ФАГОЦИТОЗ (НЕЗАВЕРШЁННЫЙ ХАРАКТЕР), СПОСОБСТВУЕТ АДГЕЗИИ К КЛЕТКАМ ПИЛИ (ФИМБРИИ) СПОСОБСТВУЮТ АДГЕЗИИ К КЛЕТКАМ. СПЕЦИФИЧНЫ ЦПМ КЛЕТОК ЦИЛИНДРИЧЕСКОГО ЭПИТЕЛИЯ

ГОНОКОККИ ЭКСПРЕССИРУЮТ АДГЕЗИН OPA 57, СПЕЦИФИЧНЫЙ МОЛЕКУЛАМ АДГЕЗИИ ЧЕЛОВЕКА CEACAM (carcinoembryonic antigen-related cell-adhesion molecule) НЕЙТРОФИЛОВ, ЛИМФОЦИТОВ И ДР. ЭТО ВЗАИМОДЕЙСТВИЕ В ПОСЛЕДУЮЩЕМ РЕАЛИЗУЕТСЯ В ВИДЕ ИММУНОСУПРЕССИИ

ЛПС КЛЕТОЧНОЙ СТЕНКИ – ЭНДОТОКСИН – ОКАЗЫВАЕТ ПАТОГЕННОЕ ДЕЙСТВИЕ РЕДКО, ЛИШЬ ПРИ ГЕНЕРАЛИЗОВАННЫХ ФОРМАХ ГОНОКОККОВОЙ ИНФЕКЦИИ ФЕРМЕНТЫ-ТОКСИНЫ НЕЙРАМИНИДАЗА

ГОНОКОККИ ВЫЗЫВАЮТ ГОНОРЕЮ – ОСТРУЮ ИЛИ ВТОРИЧНО-ХРОНИЧЕСКУЮ ИНФЕКЦИЮ МОЧЕ-ПОЛОВОГО ТРАКТА, ПЕРЕДАВАЕМУЮ ПОЛОВЫМ ПУТЁМ, РЕЖЕ – КОНТАКТНО-БЫТОВЫМ ПУТЁМ. ГОНОРЕЯ ТАКЖЕ МОЖЕТ ПЕРЕДАВАТЬСЯ ОТ ИНФИЦИРОВАННОЙ МАТЕРИ ПРИ РОДАХ НОВОРОЖДЕННОМУ РЕБЁНКУ. В ЭТОМ СЛУЧАЕ ЧАСТО ПОРАЖАЕТСЯ КОНЪЮНКТИВА - БЛЕННОРЕЯ

ПАТОГЕНЕЗ ГОНОРЕИ СВЯЗАН С РАЗМНОЖЕНИЕМ ГОНОКОККОВ В ЧУВСТВИТЕЛЬНЫХ КЛЕТКАХ И ИХ РАЗРУШЕНИЕМ С СОПУТСТВУЮЩИМ РАЗВИТИЕМ ВОСПАЛИТЕЛЬНОЙ РЕАКЦИИ

ФАКТОРЫ ЗАЩИТЫ ОРГАНИЗМА ОТ ГОНОКОККОВОЙ ИНФЕКЦИИ ПРЕИМУЩЕСТВЕННО – МЕНТАЛЬНЫЕ РЕАКЦИИ

В ОСНОВЕ ПРОФИЛАКТИКИ – ПРИМЕНЕНИЕ БАРЬЕРНЫХ СРЕДСТВ ПРИ ПОЛОВЫХ КОНТАКТАХ И АНТИСЕПТИЧЕСКАЯ ОБРАБОТКА ПОСЛЕ СОМНИТЕЛЬНЫХ ПОЛОВЫХ КОНТАКТОВ. ЛЕЧЕНИЕ – АНТИБИОТИКИ

ДИАГНОСТИКА ОСТРОЙ ГОНОРЕИ ОСУЩЕСТВЛЯЕТСЯ МИКРОСКОПИЧЕСКИМ МЕТОДОМ, ХРОНИЧЕСКОЙ ГОНОРЕИ – КУЛЬТУРАЛЬНЫМ МЕТОДОМ.
Курс лекций - кокки.ppt